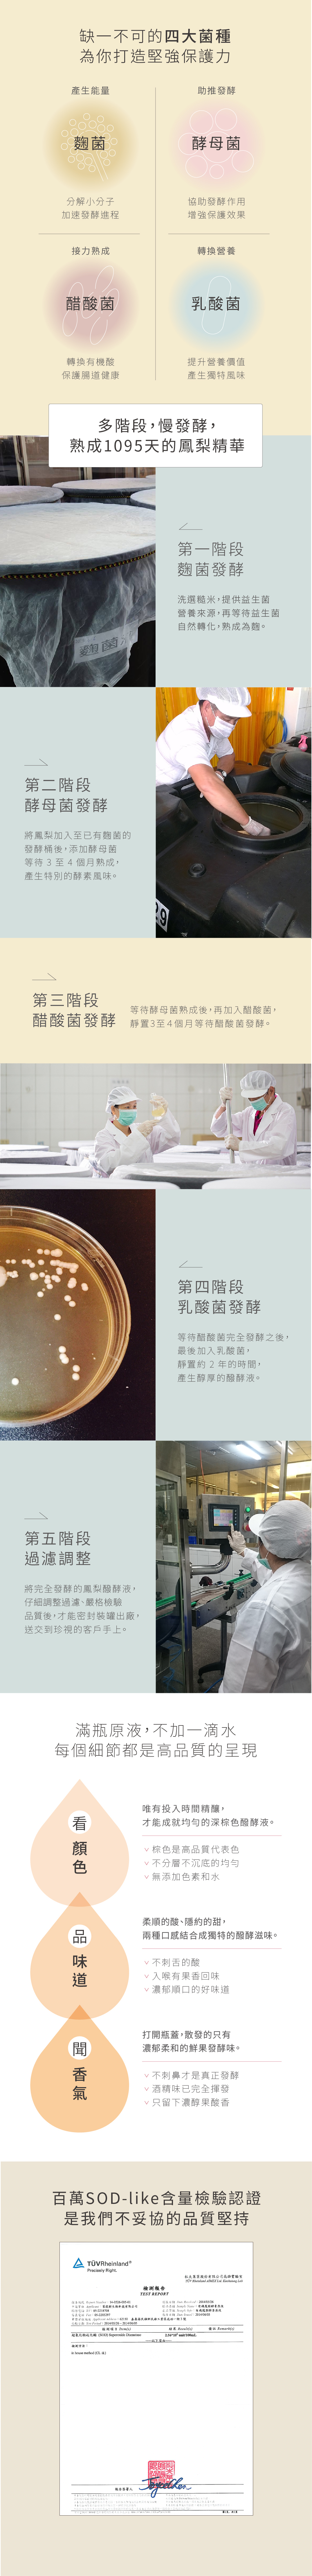

商品描述
全新鳳梨醱酵液精簡包裝上市!
支持永續,一起來改變!
請放心,品質不變,內容依然如一,但我們減少了71%紙材包裝!
這個轉變不僅讓我們的產品更環保,還能減少對地球的負擔。
期待您的支持,一同邁向更綠色的未來!
#Wholesome life #厚生生活





3年的等待,
四階段的自然發酵過程,
每一層把關都是讓你身體發笑的關鍵,
每一口純粹都會讓你從體內會心一笑。
豐富營養、調整體質、營養補給、維持健康
有機糙米及蔬果作為基底液態發酵來釀造糙米洗滌初步發芽後才製作。
選用民雄富含豐富維生素C的鳳梨汁,以單一獨立桶槽分開發酵熟成,進行四階段釀造製程,
植入麴菌、酵母菌、醋酸菌、乳酸菌等多樣菌種於溫控環境發酵熟成,以及靜置發酵出豐富優質酵素。
品名:旺萊山鳳梨醱酵液
成分:異麥芽寡糖、鳳梨、黑糖、糙米
容 量:720ml
保存期限:未開封五年
有效日期:標示於瓶貼
原產地:台灣
委託製造商:菩提樹生物科技股份有限公司民雄廠
地址:嘉義縣民雄工業區成功一街3號
電話:(05)2218708
工廠登記證:100-00062
負責廠商:三合美食品股份有限公司嘉義廠
地址:嘉義縣民雄鄉北斗村民雄工業區中正路39號
客服專線:0800-520-796
www.pineapplehill.com.tw
食用方法:每日食用30-60ml稀釋3-5倍的冷水或溫開水,
切勿用高於40度C水温的開水沖泡,以避免破壞醱酵液活性。
温馨提示:
1.胃不好者,請於餐後食用,食用醱酵液平日配合多喝水。
2.加水稀釋過後的醱酵液,請務必儘快飲用完畢。
3.醱酵原液經檢驗含有SOD-like,每日飲用有助於調整體質、促進新陳代謝。
保存方法:
置於陰涼乾燥處,不可傾倒或劇烈搖晃,開瓶後請儘快飲用
完畢或放置冰箱冷藏。
注意事項:
本產品因是天然食品微生物釀造而成,隨時日會有沉澱物或
漂浮物,顏色亦會有所差異,請安心飲用。
【關於鳳梨醱酵液的疑問】
Q:請問鳳梨醱酵液要怎麼泡呢?一次要喝多少?
A:建議每日飲用30至60cc的鳳梨醱酵液,並以3至5倍的冷水或溫開水稀釋後,就可以品嘗飲用囉!
但要特別注意勿使用高於40度的熱水,以免破壞醱酵液活性喔。
Q:請問鳳梨醱酵液什麼時候喝比較好呢?
A:鳳梨醱酵液就像日常飲品一樣,飯前或飯後都可以喝,但若平常腸胃較敏感,建議在飯後喝會比較適合。
Q:鳳梨醱酵液要怎麼保存?
A:由於鳳梨醱酵液是以新鮮鳳梨釀造而成,所以建議開封後盡速飲用完畢,或至於冰箱冷藏內保存,以免變質或失去最佳風味。
Q:請問小孩子可以喝嗎?
A:小朋友的腸胃較脆弱敏感,因此不建議嬰幼兒飲用,三歲以上的孩童則建議半量食用。
Q:什麼樣的人喝鳳梨醱酵液要特別注意呢?
A:腎臟病及糖尿病患者,請在食用前諮詢醫生。



3年的等待,
四階段的自然發酵過程,
每一層把關都是讓你身體發笑的關鍵,
每一口純粹都會讓你從體內會心一笑。
豐富營養、調整體質、營養補給、維持健康
有機糙米及蔬果作為基底液態發酵來釀造糙米洗滌初步發芽後才製作。
選用民雄富含豐富維生素C的鳳梨汁,以單一獨立桶槽分開發酵熟成,進行四階段釀造製程,
植入麴菌、酵母菌、醋酸菌、乳酸菌等多樣菌種於溫控環境發酵熟成,以及靜置發酵出豐富優質酵素。
品名:旺萊山鳳梨醱酵液
成分:異麥芽寡糖、鳳梨、黑糖、糙米
容 量:720ml
保存期限:未開封五年
有效日期:標示於瓶貼
原產地:台灣
委託製造商:菩提樹生物科技股份有限公司民雄廠
地址:嘉義縣民雄工業區成功一街3號
電話:(05)2218708
工廠登記證:100-00062
負責廠商:三合美食品股份有限公司嘉義廠
地址:嘉義縣民雄鄉北斗村民雄工業區中正路39號
客服專線:0800-520-796
www.pineapplehill.com.tw
食用方法:每日食用30-60ml稀釋3-5倍的冷水或溫開水,
切勿用高於40度C水温的開水沖泡,以避免破壞醱酵液活性。
温馨提示:
1.胃不好者,請於餐後食用,食用醱酵液平日配合多喝水。
2.加水稀釋過後的醱酵液,請務必儘快飲用完畢。
3.醱酵原液經檢驗含有SOD-like,每日飲用有助於調整體質、促進新陳代謝。
保存方法:
置於陰涼乾燥處,不可傾倒或劇烈搖晃,開瓶後請儘快飲用
完畢或放置冰箱冷藏。
注意事項:
本產品因是天然食品微生物釀造而成,隨時日會有沉澱物或
漂浮物,顏色亦會有所差異,請安心飲用。
【關於鳳梨醱酵液的疑問】
Q:請問鳳梨醱酵液要怎麼泡呢?一次要喝多少?
A:建議每日飲用30至60cc的鳳梨醱酵液,並以3至5倍的冷水或溫開水稀釋後,就可以品嘗飲用囉!
但要特別注意勿使用高於40度的熱水,以免破壞醱酵液活性喔。
Q:請問鳳梨醱酵液什麼時候喝比較好呢?
A:鳳梨醱酵液就像日常飲品一樣,飯前或飯後都可以喝,但若平常腸胃較敏感,建議在飯後喝會比較適合。
Q:鳳梨醱酵液要怎麼保存?
A:由於鳳梨醱酵液是以新鮮鳳梨釀造而成,所以建議開封後盡速飲用完畢,或至於冰箱冷藏內保存,以免變質或失去最佳風味。
Q:請問小孩子可以喝嗎?
A:小朋友的腸胃較脆弱敏感,因此不建議嬰幼兒飲用,三歲以上的孩童則建議半量食用。
Q:什麼樣的人喝鳳梨醱酵液要特別注意呢?
A:腎臟病及糖尿病患者,請在食用前諮詢醫生。
【相關文章閱讀】:
發酵食品對健康有什麼好處?什麼是醱酵液?那些人適合飲用?
減重真的那麼辛苦嗎?我們用對方法降低辛苦感!導致肥胖的成因?進食行為調整?有哪些健康點心幫助減重?
腸躁症無解嗎?何謂腸躁症?有那些症狀?容易導致腸躁症的人群?營養師建議:低-FODMAP飲食最有效
全新鳳梨醱酵液精簡包裝上市!
支持永續,一起來改變!
請放心,品質不變,內容依然如一,但我們減少了71%紙材包裝!
這個轉變不僅讓我們的產品更環保,還能減少對地球的負擔。
期待您的支持,一同邁向更綠色的未來!
#Wholesome life #厚生生活